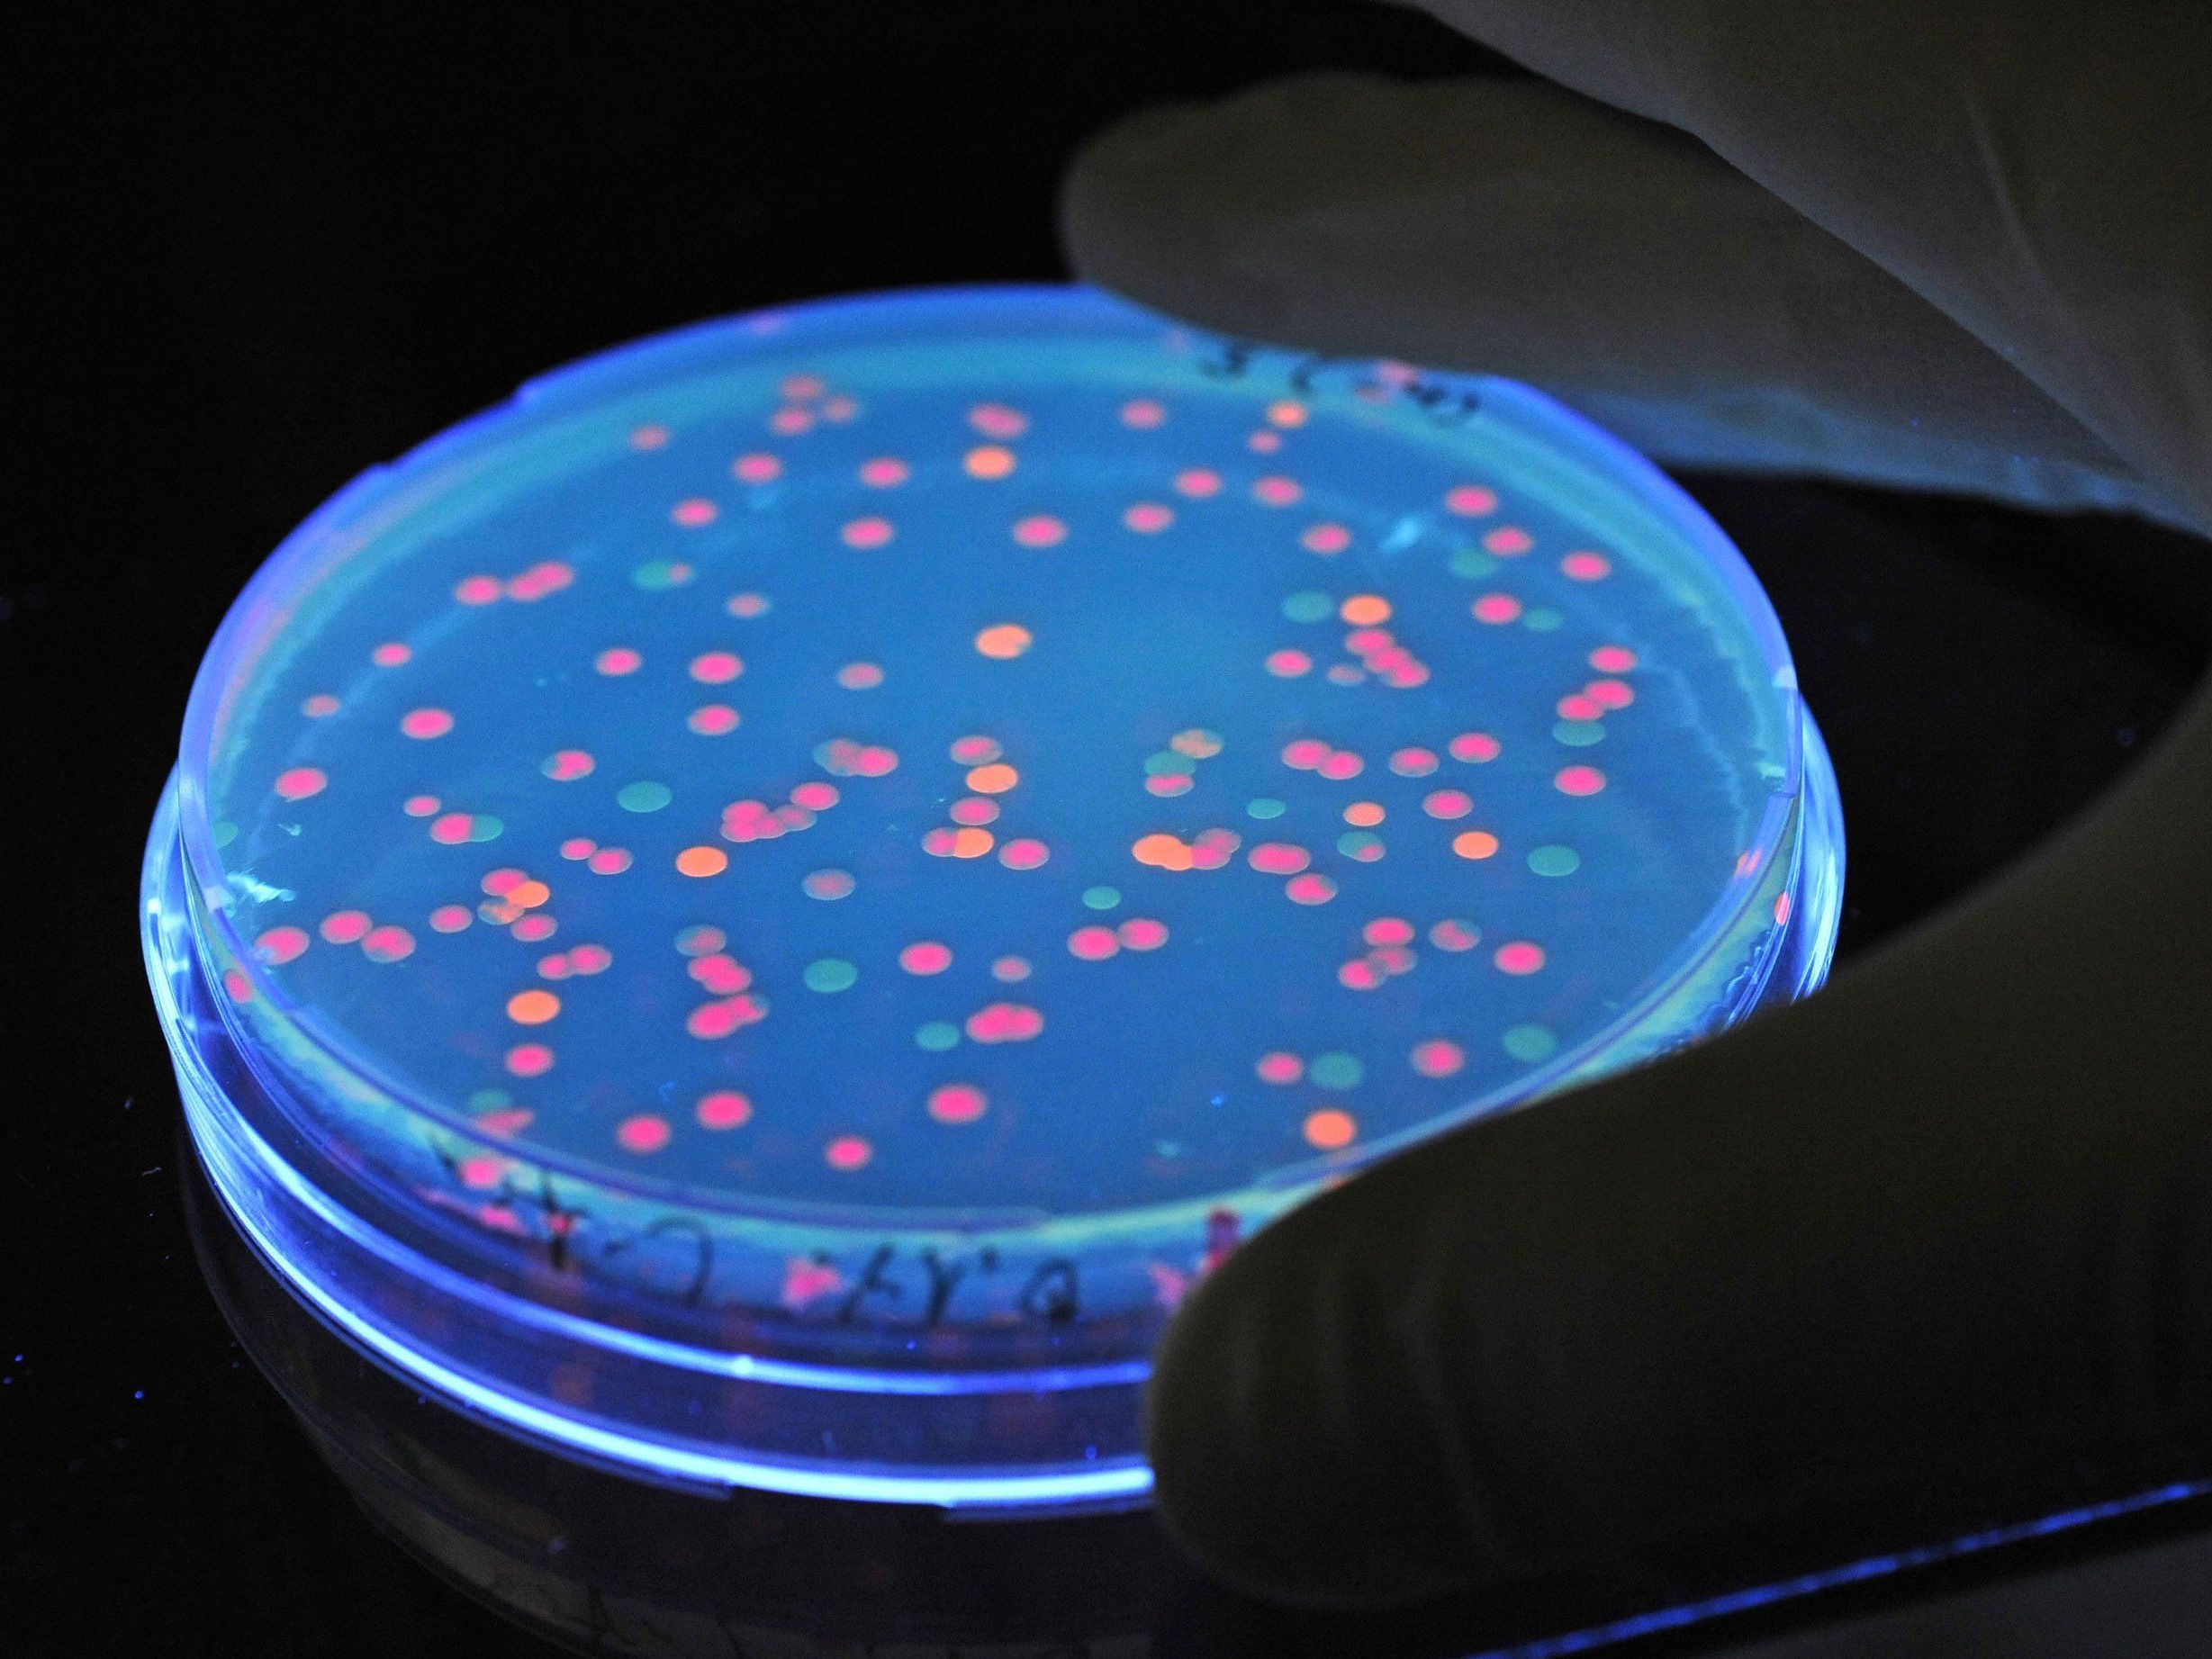

Begründeter Salmonellenverdacht bei Großveranstaltung in Wien-Wieden
Nach Angaben von Ronald Packert, Sprecher der Wiener Berufsrettung, waren bis auf zwei Personen alle älter als 18 Jahre.
Laut Wirtschaftskammer klagten bei der Abschlussfeier von “Jugend Innovativ” in der Wiedner Hauptstraße mehrere Personen über Übelkeit und erbrachen sich. Nachdem mehr als zehn Teilnehmer diese Symptome aufwiesen, verständigten die Veranstalter gegen 14.00 Uhr die Einsatzkräfte. Die Rettung war vorsorglich mit dem Katastrophenzug an Ort und Stelle. Auch die Wiener Linien stellten zwei Busse zur Verfügung, um im Notfall weitere Patienten in Spitäler zu bringen. Die 25 Betroffenen wurden jedoch alle von der Berufsrettung mit “leichter Symptomatik” in Krankenhäuser gebracht.
Behandlung nach Salmonellenverdacht bei Event in Wieden
Nun soll abgeklärt werden, ob es sich tatsächlich um Salmonellen handelt. Es wurden bereits Proben gezogen, sagte Packert.
“Über den Grund dieser Vorfälle können wir momentan nur spekulieren. Es könnte entweder ein viraler Infekt sein oder es könnte sich um Salmonellen handeln”, meinte Rupert Haberson, Sprecher der WKO. Weil in Relation zur großen Teilnehmerzahl von 200 Personen aber vergleichsweise wenige Menschen Symptome zeigten, spreche derzeit mehr für einen viralen Infekt. “Das ist die momentane Vermutung, aber sie ist nicht ärztlich bestätigt”, betonte er. Damit sich mögliche Bakterien nicht weiter ausbreiten können, wurde das Gebäude vorsorglich desinfiziert.
Patienten können Spitäler bald verlassen
Die 25 betroffenen Personen mit Brechdurchfall können die Spitäler noch am Freitag verlassen, hieß es am Abend von der Wirtschaftskammer Österreich (WKO).
“Erste ärztliche Untersuchungen haben ergeben, dass es sich wahrscheinlich um keine Salmonelleninfektion handelt”, sagte Sprecher Rupert Haberson. Ursache sei vermutlich ein viraler Infekt.
(APA)